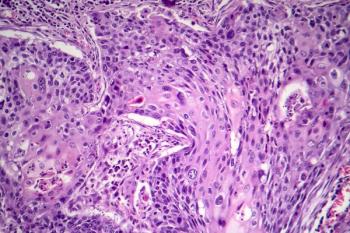

Neoadjuvant treatment with cemiplimab led to near or complete disappearance of cutaneous squamous cell carcinoma in almost 64% of patients set to undergo surgery.

Neoadjuvant treatment with cemiplimab led to near or complete disappearance of cutaneous squamous cell carcinoma in almost 64% of patients set to undergo surgery.

Single-agent pembrolizumab yielded robust antitumor activity in patients with locally advanced or recurrent/metastatic cutaneous squamous cell carcinoma.
Published: November 4th 2022 | Updated: